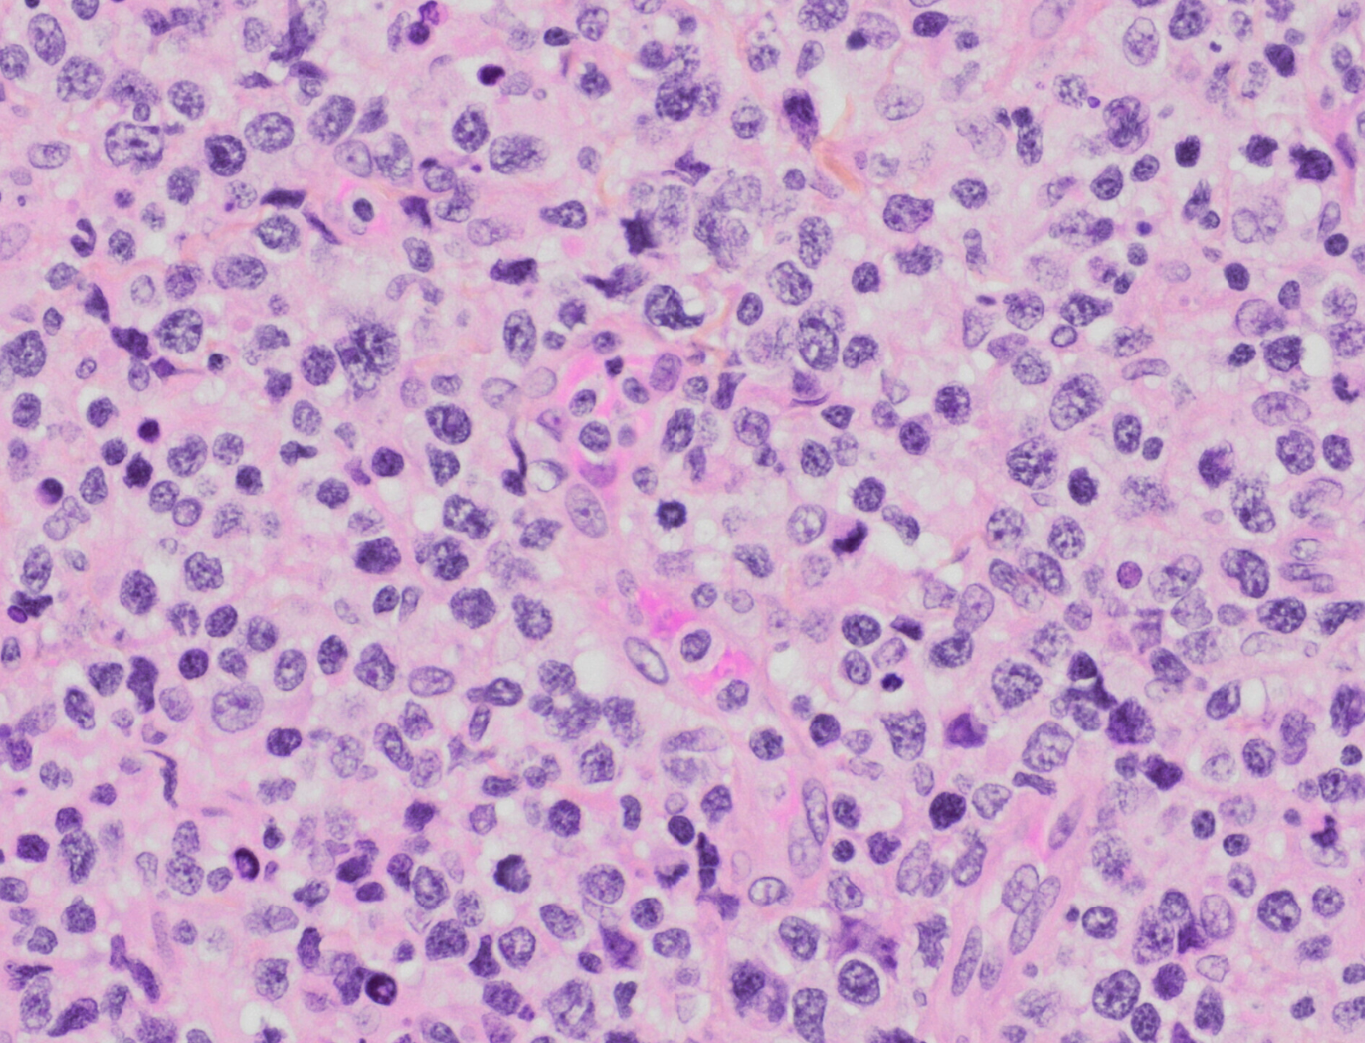

Extranodal NK/T-cell lymphoma
Haematolymphoid Tumours (WHO Classification, 5th ed.)
Primary Authors*
Teodora Popa, MD, Queen's University
Amanda Xu, MD, Queen's University
WHO Classification of Disease
| Structure | Disease |
|---|---|
| Book | Haematolymphoid Tumours (5th ed.) |
| Category | T-cell and NK-cell lymphoid proliferations and lymphomas |
| Family | Mature T-cell and NK-cell neoplasms |
| Type | EBV-positive NK-cell and T-cell lymphomas |
| Subtype(s) | Extranodal NK/T-cell lymphoma |
Definition / Description of Disease
- Lymphoma of NK or T-cell lineage strongly associated with Epstein-Barr virus[1]. The lineage (NK or T-cell) has no clinical significance[2].
- Divided into nasal and non-nasal types, the latter most often occurring in the skin and intestinal tract[3][1].
- It is a destructive angiocentric disease characterized by vascular destruction and necrosis[4].
- Differential diagnosis: sinonasal carcinomas and other lymphomas of the nasal cavity, such as diffuse large B-cell lymphoma[5].
Synonyms / Terminology
Extranodal NK/T-cell lymphoma, nasal type
EBV-positive extranodal NK/T-cell lymphoma
Not recommended: angiocentric lymphoma; lethal midline granuloma (historical)
Epidemiology / Prevalence
- Most prevalent in East Asia and Latin America.
- Represents less than 1% of non-Hodgkin lymphomas in the United States
- Highest incidence among Asian Pacific Islanders and Hispanic populations[6].
Clinical Features
| Signs and Symptoms | Nasal mass, nasal obstruction, nasal bleeding
Hoarseness, dysphagia, halitosis, airway obstruction, dysphonia Abdominal pain, GI bleeding, bowel perforation[7] B symptoms (fever, weight loss, night sweats) associated with higher clinical stage[8] |
| Laboratory Findings | No specific findings
Cytopenias |
Sites of Involvement
- Most are nasal type involving the upper aerodigestive tract
- Extranasal type may involve skin, testis, and gastrointestinal tract[7].
- Bone marrow involvement is uncommon[9].
Morphologic Features

- Diffuse infiltrate composed of admixture of small, medium, or large and anaplastic cells.
- Cells have irregularly folded nuclei and moderate pale cytoplasm.
- Loss of mucosal glands.
- Angiocentric and angiodestructive growth pattern with coagulative necrosis.
- Usually see apoptotic cells and mitotic figures
Pitfalls:
- Mucosal ulceration and superimposed inflammation can mimic an inflammatory process, particularly in less aggressive cases[10].
- Pseudoepitheliomatous hyperplasia of the overlying mucosal epithelium can mimic squamous cell carcinoma[11][12].
Immunophenotype

| Finding | Marker |
|---|---|
| Positive (universal) | EBER / EBV |
| Positive (majority) | cytoplasmic CD3ε, CD2, CD56, granzyme B, and TIA-1 |
| Positive (subset) | TCR αβ/γδ, HLA-DR, CD25, pSTAT3, CXCL13, IRF4/MUM1, CD16, Fas, FasL, MATK, CD30[13][14][15][16][17][18][19]. |
| Negative (universal) | CD4, CD8 |
| Negative (subset) | Surface CD3 (subset of T-cell lineage)[7] |
Chromosomal Rearrangements (Gene Fusions)
| Chromosomal Rearrangement | Genes in Fusion (5’ or 3’ Segments) | Pathogenic Derivative | Prevalence | Diagnostic Significance (Yes, No or Unknown) | Prognostic Significance (Yes, No or Unknown) | Therapeutic Significance (Yes, No or Unknown) | Notes |
|---|---|---|---|---|---|---|---|
| N/A | N/A | N/A | N/A | N/A | N/A | N/A | N/A |
Individual Region Genomic Gain / Loss / LOH
| Chr # | Gain / Loss / Amp / LOH | Minimal Region Genomic Coordinates [Genome Build] | Minimal Region Cytoband | Diagnostic Significance (Yes, No or Unknown) | Prognostic Significance (Yes, No or Unknown) | Therapeutic Significance (Yes, No or Unknown) | Notes |
|---|---|---|---|---|---|---|---|
| 6 | Loss | 6q21-25[20][21] | Unknown | Unknown | Unknown | This locus harbours multiple candidate tumour suppressor genes including ATG5, AIM1, PRDM1, PTPRK, HACE1, and FOXO3[22][23][24]. |
Other less common chromosomal alterations include gain of 1p, 2q, 6p, 10q, 11q, 12q, 13q, 17q, 19p, 20q, and Xp; and loss of 1p36, 2p16, 4q12, 4q31-32, 5p14, 5q34-35, 6q13-14, 6q16-27, 11q22-23, 12q, 13q12-14, 13q14-34, 17p13, and entire chromosome X[25][26][27][28][29].
Characteristic Chromosomal Patterns
| Chromosomal Pattern | Diagnostic Significance (Yes, No or Unknown) | Prognostic Significance (Yes, No or Unknown) | Therapeutic Significance (Yes, No or Unknown) | Notes |
|---|---|---|---|---|
| Isochromosome 6p[30] | Unknown | Unknown | Unknown | N/A |
| Isochromosome 7q[31] | Unknown | Unknown | Unknown | N/A |
Gene Mutations (SNV / INDEL)
| Gene; Genetic Alteration | Presumed Mechanism (Tumor Suppressor Gene [TSG] / Oncogene / Other) | Prevalence (COSMIC / TCGA / Other) | Concomitant Mutations | Mutually Exclusive Mutations | Diagnostic Significance (Yes, No or Unknown) | Prognostic Significance (Yes, No or Unknown) | Therapeutic Significance (Yes, No or Unknown) | Notes |
|---|---|---|---|---|---|---|---|---|
| JAK3[32][33] | Oncogene | 35.4%[32] | Pan-JAK and selective JAK3 inhibitors have been suggested as potential therapeutic options[32][34]. Clinical trials evaluating JAK inhibitors are in progress. | |||||
| STAT3[35][36][37] | Oncogene | 26%[37] | STAT3 inhibitor may have potential therapeutic benefit in patients with STAT3 activating mutation[38]. | |||||
| STAT5B[35][36] | Oncogene | |||||||
| PTPRK[24] | Other (acts on JAK/STAT pathway; underexpression leads to STAT3 activation[24]) | |||||||
| MYC[39] | Oncogene | |||||||
| RUNX3[40] | ||||||||
| PDGFRA[41] | Oncogene | |||||||
| EZH2[42] | Oncogene | |||||||
| DDX3X[35] | Other (RNA helicase) | 20%[35] | ||||||
| TP53[35] | Tumor suppressor gene | 24-62%[43][44] | Yes, associated with advanced stage disease[43]. | |||||
| MGA[35] | Tumor suppressor gene | |||||||
| PRDM1[45][23][46] | Tumor suppressor gene | |||||||
| ATG5[45] | Tumor suppressor gene | |||||||
| AIM1[45] | Tumor suppressor gene | |||||||
| FOXO3[45][23] | Tumor suppressor gene | |||||||
| HACE1[45][41] | Tumor suppressor gene |
Note: A more extensive list of mutations can be found in cBioportal (https://www.cbioportal.org/), COSMIC (https://cancer.sanger.ac.uk/cosmic), ICGC (https://dcc.icgc.org/) and/or other databases. When applicable, gene-specific pages within the CCGA site directly link to pertinent external content.
Epigenomic Alterations
A 2015 study by Lu, et al uncovered recurrent mutations in the RNA helicase gene DDX3X and other epigenetic modifiers including KMT2D (MLL2), ARID1A, EP300, and ASXL3[35].
Similarly, a 2015 study by Lee, et al reported that histone modification-related genes, including BCOR and KMT2D (MLL2), accounted for 38.2% of 34 ENKTL samples by next-generation sequencing[37].
Genes and Main Pathways Involved
Huang, et al described deregulation of several signaling pathways in NK T-cell lymphoma, main ones listed below[41]. A review by De Mel, et al, also outlines key molecular pathways involved in the pathogenesis of ENKTL[47].
| Gene; Genetic Alteration | Pathway | Pathophysiologic Outcome |
|---|---|---|
| JAK3, STAT3, and STAT5B; Activating mutations | JAK/STAT pathway | Increased cell growth and proliferation |
| MYC, RUNX3 | MYC | Increased cell proliferation and survival |
| AKT and related genes | AKT pathway | Increased cell growth, proliferation and survival |
| NF-κB related genes | NF-κB pathway | Increased cell proliferation |
| PDGFRA | PDGF pathway | Increased cell proliferation and survival |
| NOTCH1 | NOTCH1 pathway | Increased cell proliferation |
| AURKA | Aurora kinase pathway[39] | Increased cell proliferation and cell cycle dysregulation |
Genetic Diagnostic Testing Methods
- Select cases may require TCR gene rearrangement studies; otherwise, not routinely performed.
- EBV PCR testing may be used for disease monitoring
Familial Forms
N/A
Additional Information
N/A
Links
5th edition World Health Organization (WHO) classification system
References
- ↑ 1.0 1.1 Jaffe, E. S.; et al. (1999-01). "Extranodal peripheral T-cell and NK-cell neoplasms". American Journal of Clinical Pathology. 111 (1 Suppl 1): S46–55. ISSN 0002-9173. PMID 9894469. Check date values in:
|date=(help) - ↑ Wang, Hua; et al. (2021-09). "NK-/T-cell lymphomas". Leukemia. 35 (9): 2460–2468. doi:10.1038/s41375-021-01313-2. ISSN 1476-5551. PMC 8410593 Check
|pmc=value (help). PMID 34117356 Check|pmid=value (help). Check date values in:|date=(help) - ↑ Chan J. K. C., et al., (2017). Extranodal NK/T-cell lymphoma, nasal type, in World Health Organization Classification of Tumours of Haematopoietic and Lymphoid Tissues, Revised 4th edition. Swerdlow SH, Campo E, Harris NL, Jaffe ES, Pileri SA, Stein H, Thiele J, Arber DA, Hasserjian RP, Le Beau MM, Orazi A, and Siebert R, Editors. Revised 4th Edition. IARC Press: Lyon, France, p.368-371.
- ↑ Aviles, A.; et al. (1992). "Angiocentric T-cell lymphoma of the nose, paranasal sinuses and hard palate". Hematological Oncology. 10 (3–4): 141–147. doi:10.1002/hon.2900100303. ISSN 0278-0232. PMID 1398510.
- ↑ Steele, Toby O.; et al. (2016-09). "Lymphoma of the nasal cavity and paranasal sinuses: A case series". American Journal of Rhinology & Allergy. 30 (5): 335–339. doi:10.2500/ajra.2016.30.4347. ISSN 1945-8932. PMID 27657899. Check date values in:
|date=(help) - ↑ Haverkos, Bradley M.; et al. (2016-12). "Extranodal NK/T-cell lymphoma, nasal type (ENKTL-NT): An update on epidemiology, clinical presentation, and natural history in North American and European cases". Current hematologic malignancy reports. 11 (6): 514–527. doi:10.1007/s11899-016-0355-9. ISSN 1558-8211. PMC 5199232. PMID 27778143. Check date values in:
|date=(help) - ↑ 7.0 7.1 7.2 Thida AM, Gohari P. Extranodal NK-Cell Lymphoma. [Updated 2023 Jul 17]. In: StatPearls [Internet]. Treasure Island (FL): StatPearls Publishing; 2024 Jan-. Available from: https://www.ncbi.nlm.nih.gov/books/NBK559207/
- ↑ Takahara, Miki; et al. (2021-06-25). "Extranodal NK/T-Cell Lymphoma, Nasal Type: Genetic, Biologic, and Clinical Aspects with a Central Focus on Epstein-Barr Virus Relation". Microorganisms. 9 (7): 1381. doi:10.3390/microorganisms9071381. ISSN 2076-2607. PMC 8304202 Check
|pmc=value (help). PMID 34202088 Check|pmid=value (help). - ↑ Wong, K. F.; et al. (2001-02). "Bone marrow involvement by nasal NK cell lymphoma at diagnosis is uncommon". American Journal of Clinical Pathology. 115 (2): 266–270. doi:10.1309/E5PR-6A9R-Q02N-8QVW. ISSN 0002-9173. PMID 11211616. Check date values in:
|date=(help) - ↑ Devins, K., Schuster, S.J., Caponetti, G.C. et al. Rare case of low-grade extranodal NK/T-cell lymphoma, nasal type, arising in the setting of chronic rhinosinusitis and harboring a novel N-terminal KIT mutation. Diagn Pathol 13, 92 (2018). https://doi.org/10.1186/s13000-018-0765-1
- ↑ Ling, Yi-Hong; et al. (2015-09). "Pseudoepitheliomatous hyperplasia mimicking invasive squamous cell carcinoma in extranodal natural killer/T-cell lymphoma: a report of 34 cases". Histopathology. 67 (3): 404–409. doi:10.1111/his.12656. ISSN 1365-2559. PMID 25619876. Check date values in:
|date=(help) - ↑ Xiang, Chun-Xiang; et al. (2019-07). "Laryngeal Extranodal Nasal-type Natural Killer/T-cell Lymphoma: A Clinicopathologic Study of 31 Cases in China". The American Journal of Surgical Pathology. 43 (7): 995–1004. doi:10.1097/PAS.0000000000001266. ISSN 1532-0979. PMID 31045893. Check date values in:
|date=(help) - ↑ Li, Shaoying; et al. (2013-01). "Extranodal NK/T-cell lymphoma, nasal type: a report of 73 cases at MD Anderson Cancer Center". The American Journal of Surgical Pathology. 37 (1): 14–23. doi:10.1097/PAS.0b013e31826731b5. ISSN 1532-0979. PMID 23232851. Check date values in:
|date=(help) - ↑ Jhuang, Jie-Yang; et al. (2015-02). "Extranodal natural killer/T-cell lymphoma, nasal type in Taiwan: a relatively higher frequency of T-cell lineage and poor survival for extranasal tumors". Human Pathology. 46 (2): 313–321. doi:10.1016/j.humpath.2014.11.008. ISSN 1532-8392. PMID 25554090. Check date values in:
|date=(help) - ↑ Pongpruttipan, Tawatchai; et al. (2012-04). "Extranodal NK/T-cell lymphoma, nasal type, includes cases of natural killer cell and αβ, γδ, and αβ/γδ T-cell origin: a comprehensive clinicopathologic and phenotypic study". The American Journal of Surgical Pathology. 36 (4): 481–499. doi:10.1097/PAS.0b013e31824433d8. ISSN 1532-0979. PMID 22314189. Check date values in:
|date=(help) - ↑ Jaffe, E. S.; et al. (1996-01). "Report of the Workshop on Nasal and Related Extranodal Angiocentric T/Natural Killer Cell Lymphomas. Definitions, differential diagnosis, and epidemiology". The American Journal of Surgical Pathology. 20 (1): 103–111. doi:10.1097/00000478-199601000-00012. ISSN 0147-5185. PMID 8540601. Check date values in:
|date=(help) - ↑ Ohshima, K.; et al. (1997-11). "Nasal T/NK cell lymphomas commonly express perforin and Fas ligand: important mediators of tissue damage". Histopathology. 31 (5): 444–450. doi:10.1046/j.1365-2559.1997.2880887.x. ISSN 0309-0167. PMID 9416485. Check date values in:
|date=(help) - ↑ Takata, Katsuyoshi; et al. (2015-01). "Primary cutaneous NK/T-cell lymphoma, nasal type and CD56-positive peripheral T-cell lymphoma: a cellular lineage and clinicopathologic study of 60 patients from Asia". The American Journal of Surgical Pathology. 39 (1): 1–12. doi:10.1097/PAS.0000000000000312. ISSN 1532-0979. PMID 25188863. Check date values in:
|date=(help) - ↑ Kuo, Tseng-Tong; et al. (2004-10). "Nasal NK/T cell lymphoma in Taiwan: a clinicopathologic study of 22 cases, with analysis of histologic subtypes, Epstein-Barr virus LMP-1 gene association, and treatment modalities". International Journal of Surgical Pathology. 12 (4): 375–387. doi:10.1177/106689690401200410. ISSN 1066-8969. PMID 15494863. Check date values in:
|date=(help) - ↑ Wong, K. F.; et al. (1997-09). "Identification of del(6)(q21q25) as a recurring chromosomal abnormality in putative NK cell lymphoma/leukaemia". British Journal of Haematology. 98 (4): 922–926. doi:10.1046/j.1365-2141.1997.3223139.x. ISSN 0007-1048. PMID 9326190. Check date values in:
|date=(help) - ↑ Ohshima, Koichi; et al. (2002-02). "Analysis of chromosome 6q deletion in EBV-associated NK cell leukaemia/lymphoma". Leukemia & Lymphoma. 43 (2): 293–300. doi:10.1080/10428190290006062. ISSN 1042-8194. PMID 11999560. Check date values in:
|date=(help) - ↑ Iqbal, J.; et al. (2009-06). "Genomic analyses reveal global functional alterations that promote tumor growth and novel tumor suppressor genes in natural killer-cell malignancies". Leukemia. 23 (6): 1139–1151. doi:10.1038/leu.2009.3. ISSN 1476-5551. PMID 19194464. Check date values in:
|date=(help) - ↑ 23.0 23.1 23.2 Karube, Kennosuke; et al. (2011-09-22). "Identification of FOXO3 and PRDM1 as tumor-suppressor gene candidates in NK-cell neoplasms by genomic and functional analyses". Blood. 118 (12): 3195–3204. doi:10.1182/blood-2011-04-346890. ISSN 1528-0020. PMID 21690554.
- ↑ 24.0 24.1 24.2 Chen, Yun-Wen; et al. (2015-03-05). "Receptor-type tyrosine-protein phosphatase κ directly targets STAT3 activation for tumor suppression in nasal NK/T-cell lymphoma". Blood. 125 (10): 1589–1600. doi:10.1182/blood-2014-07-588970. ISSN 1528-0020. PMID 25612622.
- ↑ Nakashima, Yasuhiro; et al. (2005-11). "Genome-wide array-based comparative genomic hybridization of natural killer cell lymphoma/leukemia: different genomic alteration patterns of aggressive NK-cell leukemia and extranodal Nk/T-cell lymphoma, nasal type". Genes, Chromosomes & Cancer. 44 (3): 247–255. doi:10.1002/gcc.20245. ISSN 1045-2257. PMID 16049916. Check date values in:
|date=(help) - ↑ Siu, L. L.; et al. (2000-12). "Consistent patterns of allelic loss in natural killer cell lymphoma". The American Journal of Pathology. 157 (6): 1803–1809. doi:10.1016/S0002-9440(10)64818-3. ISSN 0002-9440. PMC 1885756. PMID 11106552. Check date values in:
|date=(help) - ↑ Siu, L. L.; et al. (1999-11). "Comparative genomic hybridization analysis of natural killer cell lymphoma/leukemia. Recognition of consistent patterns of genetic alterations". The American Journal of Pathology. 155 (5): 1419–1425. doi:10.1016/S0002-9440(10)65454-5. ISSN 0002-9440. PMC 1866965. PMID 10550295. Check date values in:
|date=(help) - ↑ Wong, K. F.; et al. (1999-07). "Cytogenetic abnormalities in natural killer cell lymphoma/leukaemia--is there a consistent pattern?". Leukemia & Lymphoma. 34 (3–4): 241–250. doi:10.3109/10428199909050949. ISSN 1042-8194. PMID 10439361. Check date values in:
|date=(help) - ↑ Ko, Y. H.; et al. (2001-04-15). "Comparative genomic hybridization study of nasal-type NK/T-cell lymphoma". Cytometry. 46 (2): 85–91. doi:10.1002/cyto.1069. ISSN 0196-4763. PMID 11309817.
- ↑ Tien, H. F.; et al. (1997-06). "Clonal chromosomal abnormalities as direct evidence for clonality in nasal T/natural killer cell lymphomas". British Journal of Haematology. 97 (3): 621–625. doi:10.1046/j.1365-2141.1997.752711.x. ISSN 0007-1048. PMID 9207410. Check date values in:
|date=(help) - ↑ Feldman, Andrew L.; et al. (2008-08). "Incidence of TCR and TCL1 gene translocations and isochromosome 7q in peripheral T-cell lymphomas using fluorescence in situ hybridization". American Journal of Clinical Pathology. 130 (2): 178–185. doi:10.1309/PNXUKA1CFJMVGCN1. ISSN 0002-9173. PMC 3625137. PMID 18628085. Check date values in:
|date=(help) - ↑ 32.0 32.1 32.2 Koo, Ghee Chong; et al. (2012-07). "Janus kinase 3-activating mutations identified in natural killer/T-cell lymphoma". Cancer Discovery. 2 (7): 591–597. doi:10.1158/2159-8290.CD-12-0028. ISSN 2159-8290. PMID 22705984. Check date values in:
|date=(help) - ↑ Bouchekioua, A.; et al. (2014-02). "JAK3 deregulation by activating mutations confers invasive growth advantage in extranodal nasal-type natural killer cell lymphoma". Leukemia. 28 (2): 338–348. doi:10.1038/leu.2013.157. ISSN 1476-5551. PMID 23689514. Check date values in:
|date=(help) - ↑ Nairismägi, M.-L.; et al. (2018-05). "Oncogenic activation of JAK3-STAT signaling confers clinical sensitivity to PRN371, a novel selective and potent JAK3 inhibitor, in natural killer/T-cell lymphoma". Leukemia. 32 (5): 1147–1156. doi:10.1038/s41375-017-0004-x. ISSN 1476-5551. PMC 5940653. PMID 29434279. Check date values in:
|date=(help) - ↑ 35.0 35.1 35.2 35.3 35.4 35.5 35.6 Jiang, Lu; et al. (2015-09). "Exome sequencing identifies somatic mutations of DDX3X in natural killer/T-cell lymphoma". Nature Genetics. 47 (9): 1061–1066. doi:10.1038/ng.3358. ISSN 1546-1718. PMID 26192917. Check date values in:
|date=(help) - ↑ 36.0 36.1 Küçük, Can; et al. (2015-01-14). "Activating mutations of STAT5B and STAT3 in lymphomas derived from γδ-T or NK cells". Nature Communications. 6: 6025. doi:10.1038/ncomms7025. ISSN 2041-1723. PMC 7743911 Check
|pmc=value (help). PMID 25586472. - ↑ 37.0 37.1 37.2 Lee, Seungbok; et al. (2015-07-10). "Genetic alterations of JAK/STAT cascade and histone modification in extranodal NK/T-cell lymphoma nasal type". Oncotarget. 6 (19): 17764–17776. doi:10.18632/oncotarget.3776. ISSN 1949-2553. PMC 4627344. PMID 25980440.
- ↑ Wang, Yali; et al. (2023-08). "Preclinical characterization of WB737, a potent and selective STAT3 inhibitor, in natural killer/T-cell lymphoma". MedComm. 4 (4): e284. doi:10.1002/mco2.284. ISSN 2688-2663. PMC PMC10274570 Check
|pmc=value (help). PMID 37334274 Check|pmid=value (help). Check date values in:|date=(help)CS1 maint: PMC format (link) - ↑ 39.0 39.1 Ng, Siok-Bian; et al. (2011-03). "Activated oncogenic pathways and therapeutic targets in extranodal nasal-type NK/T cell lymphoma revealed by gene expression profiling". The Journal of Pathology. 223 (4): 496–510. doi:10.1002/path.2823. ISSN 1096-9896. PMID 21294123. Check date values in:
|date=(help) - ↑ Selvarajan, V.; et al. (2017-10). "RUNX3 is oncogenic in natural killer/T-cell lymphoma and is transcriptionally regulated by MYC". Leukemia. 31 (10): 2219–2227. doi:10.1038/leu.2017.40. ISSN 1476-5551. PMC 5629367. PMID 28119527. Check date values in:
|date=(help) - ↑ 41.0 41.1 41.2 Huang, Yenlin; et al. (2010-02-11). "Gene expression profiling identifies emerging oncogenic pathways operating in extranodal NK/T-cell lymphoma, nasal type". Blood. 115 (6): 1226–1237. doi:10.1182/blood-2009-05-221275. ISSN 1528-0020. PMC 2826234. PMID 19965620.
- ↑ Yan, Junli; et al. (2016-08-18). "EZH2 phosphorylation by JAK3 mediates a switch to noncanonical function in natural killer/T-cell lymphoma". Blood. 128 (7): 948–958. doi:10.1182/blood-2016-01-690701. ISSN 1528-0020. PMID 27297789.
- ↑ 43.0 43.1 Quintanilla-Martinez, L.; et al. (2001-12). "p53 Mutations in nasal natural killer/T-cell lymphoma from Mexico: association with large cell morphology and advanced disease". The American Journal of Pathology. 159 (6): 2095–2105. doi:10.1016/S0002-9440(10)63061-1. ISSN 0002-9440. PMC 1850589. PMID 11733360. Check date values in:
|date=(help) - ↑ Hongyo, Tadashi; et al. (2005-02). "p53, K-ras, c-kit and beta-catenin gene mutations in sinonasal NK/T-cell lymphoma in Korea and Japan". Oncology Reports. 13 (2): 265–271. ISSN 1021-335X. PMID 15643509. Check date values in:
|date=(help) - ↑ 45.0 45.1 45.2 45.3 45.4 Huang, Yenlin; et al. (2013-03). "Molecular underpinning of extranodal NK/T-cell lymphoma". Best Practice & Research. Clinical Haematology. 26 (1): 57–74. doi:10.1016/j.beha.2013.04.006. ISSN 1532-1924. PMID 23768641. Check date values in:
|date=(help) - ↑ Küçük, Can; et al. (2011-12-13). "PRDM1 is a tumor suppressor gene in natural killer cell malignancies". Proceedings of the National Academy of Sciences of the United States of America. 108 (50): 20119–20124. doi:10.1073/pnas.1115128108. ISSN 1091-6490. PMC 3250125. PMID 22143801.
- ↑ de Mel, Sanjay; et al. (2019-04-02). "Molecular pathogenic pathways in extranodal NK/T cell lymphoma". Journal of Hematology & Oncology. 12 (1): 33. doi:10.1186/s13045-019-0716-7. ISSN 1756-8722. PMC 6444858. PMID 30935402.
Notes
*Primary authors will typically be those that initially create and complete the content of a page. If a subsequent user modifies the content and feels the effort put forth is of high enough significance to warrant listing in the authorship section, please contact the CCGA coordinators (contact information provided on the homepage). Additional global feedback or concerns are also welcome. *Citation of this Page: “Extranodal NK/T-cell lymphoma”. Compendium of Cancer Genome Aberrations (CCGA), Cancer Genomics Consortium (CGC), updated 10/25/2024, https://ccga.io/index.php/HAEM5:Extranodal_NK/T-cell_lymphoma.